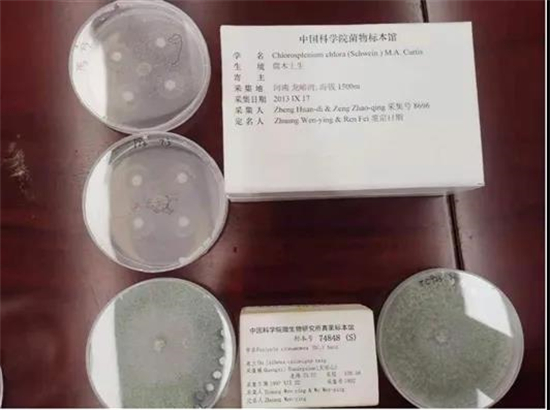

庄文颖在实验室里工作(倪思洁摄)
走过近半个世纪的科研生涯,庄文颖已经很少再去野外考察。过去,她的脚,爬过全国26个省区的荒山野岭;她的背,背过数不清的真菌标本;她的眼睛,辨认出过360多个新种。年过七旬,庄文颖的步子沉了,背微微有些弯,眼睛也时常不受控制地流出泪水。她还是习惯性地留着端庄又好打理的齐耳短发,每天出现在中国科学院微生物研究所C座4层的实验室,与真菌标本、放大镜、显微镜和她的学生为伴。
她有很多荣誉,如“中国科学院院士”“发展中国家科学院院士”“国际欧亚科学院院士”“美洲真菌学会外籍荣誉会士”;学者们曾以她的名字命名了真菌新属“文颖盘菌属”和细菌新属“海庄文颖氏菌属”;最近,在北京市委宣传部、北京市科协等部门首次联合开展的北京最美科技工作者学习宣传活动中,她被遴选为2021年北京“最美科技工作者”。但她最看重的,还是最简单的那个称谓——“菌物学家”。
30岁,她“踏上了真菌学这条路”
1968年,庄文颖20岁。响应国家号召,她到农村插队。于是,山西偏远的小村庄里,多了一位爱读书的姑娘。那段时间,只要有空余时间,她一定会抱起书本。1973年,庄文颖等来了机会。她顺利考入山西农学院,并在毕业后选择留校任教。当时,庄文颖有两个选择——昆虫学、植物病理学。“不喜欢昆虫”的她选了植物病理学。在边教边学的过程中,她发现,大约70%的植物病害是由真菌引起的,真菌有很多问题值得研究。带着问题,庄文颖考取了中国科学院研究生院硕士研究生,师从菌物学家、中国科学院微生物所研究员余永年,“踏上了真菌学这条路”。那一年, 她30岁。时间在一次次实验与思考中过得飞快,在余永年的指导下,庄文颖掌握了真菌分类学的有关研究方法,成为课题组里的顶梁柱。师生间越来越默契,庄文颖知道老师想做什么,余永年也深信庄文颖一定能做成。1983年,在课题组缺少人手的情况下,余永年还是决定送庄文颖赴美进修和攻读博士学位。他期望庄文颖今后能为我国真菌分类研究打开新局面。更大的世界在庄文颖面前铺开。在美国康奈尔大学,庄文颖读到了许多难得的真菌学文献资料,也看到了国际同行的科研效率,于是她尽可能多地压缩休息时间用来学习和工作。那段时间,庄文颖在国际期刊上发表了多篇科研成果。1988年回国后,庄文颖产生了一个念头——要让中国的真菌学走到国际舞台上去,“我要让国内学者知道,国际期刊并不是高不可攀的”。1993年,借助于中科院生物区系特别支持项目,她和十几位同行深入大巴山丛林进行野外考察。这次考察归来,在她的倡导下,团队成员在国际刊物上一口气发表了一组(7篇)论文,让中国真菌学家在国际上来了次罕见的集体亮相。

庄文颖向记者普及木霉的实用价值(倪思洁摄)
“我没做过什么轰轰烈烈的事”
上世纪80年代之后,庄文颖工作的一些时间是在野外度过的。那时的科考条件很简陋。行李装备全靠自己扛,他们下了火车要倒公共汽车,下了公共汽车还要想尽各种办法才能到达目的地,许多时间要花在路上。采集地比较潮湿,他们就要想方设法烘干标本,大家经常把整理好的真菌标本绑在烧水锅炉上烘一宿,第二天再带着烘得半湿不干的标本继续前行。艰苦的旅途却让庄文颖感觉很美好。1998年春节,她带着十几人组成考察队进入广西大龙山,开展热带地区真菌调查。进山之前,大家坐着铁皮船穿过狭长的水库,一座座人迹罕至的绿色小岛缓缓地从他们身边掠过,如诗如画。那次旅途的终点是一片原始丛林,在那里,庄文颖见到了许多从未见过的盘状真菌新种。越往前走,他们采到的标本越多,背包也越沉,可大家的脚步反倒轻盈起来。美好的记忆还有很多:广西大明山是她去过的湿度最高的地方,走路就像在腾云;新疆广袤的戈壁滩里没有路,他们一路颠簸却欢欣鼓舞……苦与乐融在一起,在她的心里不浓不淡地晕染着。“我没做过什么轰轰烈烈的事。”回忆起过去的日子,庄文颖说。但这么多年来,她早已不觉间带着考察队走遍了全国26个省区;研究了39个国家和地区的大量真菌材料;发现了新科1个、新属13个、新种360余个,澄清大量分类和命名问题;发现和筛选出了有广泛应用潜力的木霉菌株,使我国木霉资源状况面目一新;庄文颖个人还独立完成了3个属的世界专著性研究,并使我国部分类群的物种数量倍增。
庄文颖研究过的标本和菌株(倪思洁摄)
“他留下的,有用的我肯定要用”
庄文颖的办公室里有一个老旧的保温壶,那是她的老师余永年退休时清理办公室后留下的。“保温不是太好了,但还可以用。他留下的,有用的我肯定要用。”庄文颖说。老师给庄文颖留下的更宝贵的东西,是对待菌物学的热情与执着。余永年从事菌物学科研和教学50余年,在国内外30多种学术刊物上发表论文120余篇,编、著、译书20余部。2010年,余永年自知身患癌症,仍坚持组织全国学者撰写中国菌物学的百年研究史。在病痛的折磨下,余永年的工作艰辛而痛苦,而值得欣慰的是,2015年,在他病逝后的一年,《中国菌物学100年》正式出版。这份热情与执着感染着庄文颖。在带领团队率先在我国热带和西北地区开展真菌资源普查、分类、分子系统学、数据库建设等综合研究的同时,她还先后主持了“中国孢子植物志的编研”等重大项目20余项;撰写、主编著作9部,参编9部;成为国际真菌学领域的权威工具书——《真菌辞典》首位参与编写的中国籍学者。年逾七旬的她坚持在《中国大百科全书》第三版中担任生物学编委,走进中小学课堂、首都科学讲堂等公众平台授课……庄文颖的热情与执着也感染着她的学生。给学生们修改论文时,庄文颖总是从科研数据到研究结论,从遣词造句到标点符号,把修改和备注做得仔仔细细。在日常的科研工作中,她还经常手把手地指导学生实验操作,陪他们打扫实验台,带他们查阅图书文献。她的学生王新存这样评价她:“与善人居,如入兰芷之室,久而不闻其香。”
一直以来,时间是庄文颖唯一的对手。“我70多了,真菌学有好多未知领域,我还需要不断学习。”庄文颖说,她不信来生。她依在竭尽全力,尝试着把人们对真菌学的认知边界再拓宽一点。













